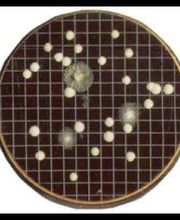

Termoidraulica Rizzi Remo & C. SNC
Installazione gas-acqua · Idraulico · Ristrutturazione
Via Strada Vecchia 1, 25070 Barghehttps://www.chimicgardaanalisirilievi.it (WEBSITE)
La Chimic Garda Analisi e Rilievi si occupa da anni di analisi chimiche ambientali. Nel nostro laboratorio si effettuano analisi chimiche e microbiologiche su acque, con particolare riferimento ai requisiti di potabilità, balneabilità, agli scarichi civili e industriali, su alimenti, superfici di lavoro, rifiuti e per bonifiche ambientali. Programmiamo inoltre corsi per il rilascio e il rinnovo del libretto sanitario. Per ogni esigenza nel settore, siamo a disposizione a Barghe, in provincia di Brescia.

Via Strada Vecchia per Preseglie, 1, 25070 Barghe
Installazione gas-acqua · Idraulico · Ristrutturazione
Via Strada Vecchia 1, 25070 BargheFabbro
Via Strada Vecchia 1, 25070 Barghe